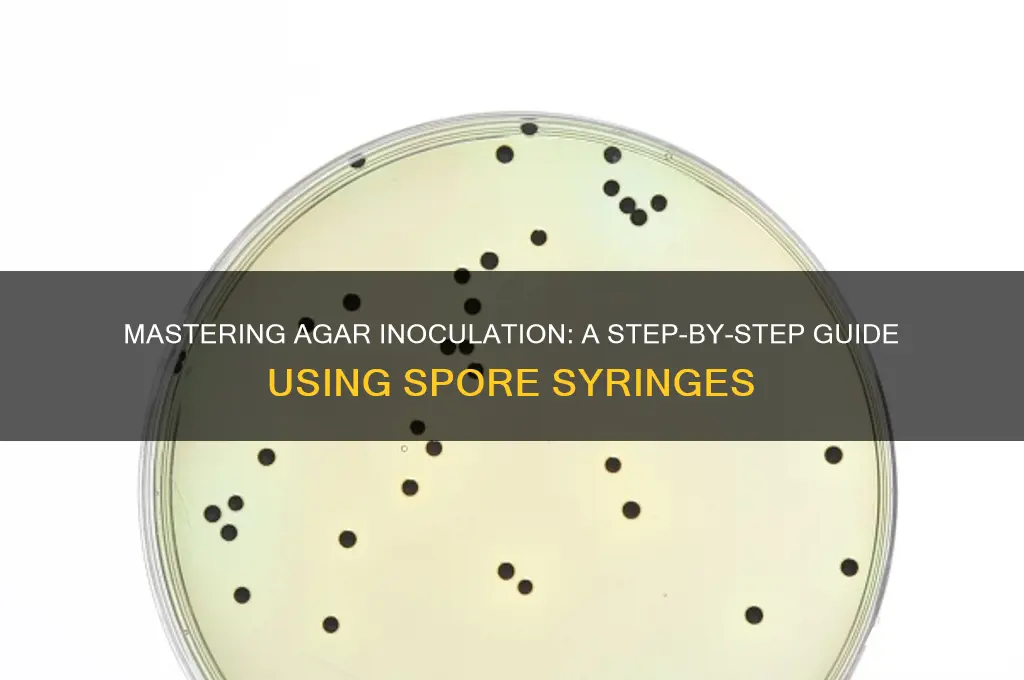
how to inoculate agar with a spore syringe

Inoculating agar with a spore syringe is a fundamental technique in mycology, allowing cultivators to grow fungi from spores in a controlled environment. This process involves transferring spores from a syringe onto a sterilized agar plate, providing a nutrient-rich medium for germination and colonization. Proper sterilization, aseptic technique, and precision are critical to prevent contamination and ensure successful growth. By following a step-by-step method—including flame sterilization of tools, careful injection of spores, and sealing the plate—cultivators can create an ideal setting for fungal development, paving the way for further research or cultivation.
What You'll Learn
- Sterilize workspace and tools to prevent contamination during the inoculation process
- Prepare agar plates by cooling them to a safe, workable temperature
- Extract spore solution carefully from the syringe without introducing impurities
- Inject spores into agar using proper technique to ensure even distribution
- Seal and incubate plates in optimal conditions for spore germination and growth

Sterilize workspace and tools to prevent contamination during the inoculation process
Contamination is the arch-nemesis of successful agar inoculation, capable of derailing weeks of effort in seconds. Even a single stray microbe can outcompete your desired fungus, rendering your experiment useless. Sterilization, therefore, isn't just a step—it's the foundation of the entire process.
The Sterilization Arsenal:
Your first line of defense is a 70% isopropyl alcohol solution. This concentration strikes the balance between efficacy and evaporation speed, ensuring surfaces dry quickly without leaving residue. Pair it with sterile gloves, a lab coat, and a face mask to minimize human-borne contaminants. For heat-resistant tools like scalpels or forceps, flaming with a Bunsen burner or alcohol lamp is ideal. Hold the tool in the flame until it glows red, then allow it to cool on a sterile surface. Glassware and metal instruments can be autoclaved at 121°C and 15 psi for 15–30 minutes, a method that uses steam under pressure to kill all microorganisms.
Workspace Preparation:
Choose a clean, clutter-free area away from high-traffic zones. If possible, work in a laminar flow hood, which provides a sterile airflow to keep particles at bay. Wipe down all surfaces with the alcohol solution, including the hood’s interior, workbench, and any equipment. Allow surfaces to air-dry completely—wiping or touching them prematurely reintroduces contaminants. Cover the area with sterile drapes or aluminum foil for added protection.
Tool Handling and Technique:
Treat your tools like they’re radioactive. Once sterilized, they must only touch sterile items or the agar itself. Avoid setting them down on non-sterile surfaces, even for a moment. When transferring the spore syringe, hold it by its capped end, and flame the injection port briefly before use. Work with deliberate, slow movements to minimize air disturbance, which can carry particles from your skin, hair, or clothing.
The Human Factor:
Even with gloves, your hands are a contamination risk. Wash them thoroughly with antibacterial soap before starting, and avoid touching your face, hair, or clothing during the process. If you must adjust your mask or gloves, do so with the opposite hand or a sterile tool. Position yourself to minimize breathing directly over the workspace, and speak sparingly—a single sneeze or cough can ruin everything.
Post-Sterilization Vigilance:
Sterilization isn’t a one-time event—it’s a mindset. Keep a spray bottle of alcohol solution nearby for spot treatments if you notice dust or debris. After inoculation, immediately dispose of used gloves, masks, and other single-use items in a biohazard bag. Autoclave reusable tools again before storing them. Think of your workspace as a temporary cleanroom, and treat every action as a potential contamination risk until the process is complete.
By treating sterilization as a meticulous, multi-layered process, you create an environment where your desired fungus can thrive uncontested. It’s not just about following steps—it’s about cultivating a culture of cleanliness that permeates every aspect of the inoculation process.
Does Spore Work on Steam? Compatibility and Performance Explained
You may want to see also

Prepare agar plates by cooling them to a safe, workable temperature
Agar plates must be cooled to a temperature that is safe for handling yet warm enough to remain liquid for inoculation. Aim for 50–55°C (122–131°F), a range that prevents burns while keeping the agar pliable. Use a thermometer to verify the temperature before proceeding, as overheating can kill spores, and underheating may cause the agar to solidify prematurely.
Cooling agar plates properly is a delicate balance of time and technique. After autoclaving and pouring the agar, allow the plates to cool in a sterile environment for 20–30 minutes. Avoid rushing this step by placing plates in a fridge or using fans, as rapid cooling can introduce contaminants or create uneven surfaces. Instead, let them rest on a clean, flat surface covered with a sterile lid or plastic wrap to maintain sterility.
The ideal temperature for inoculation is not just about safety—it’s about precision. At 50–55°C, the agar remains fluid enough to allow even distribution of spores from the syringe but solidifies quickly once spread. This ensures the spores remain viable and evenly dispersed, increasing the likelihood of successful colonization. Always wear heat-resistant gloves during handling to avoid burns and maintain aseptic conditions.
Practical tips can streamline this process. For instance, prepare multiple plates in batches to optimize cooling time, and use a sterile spatula to gently swirl the agar if it begins to set unevenly. If working with large volumes, consider using a water bath preheated to 50°C to maintain consistent temperatures. These small adjustments can significantly improve efficiency and reduce the risk of contamination or failed inoculation.
Maximizing Spore Syringe Shelf Life: Fridge Storage Tips and Duration
You may want to see also

Extract spore solution carefully from the syringe without introducing impurities
The precision of spore extraction is a critical step in the inoculation process, where a single misstep can compromise the entire culture. To begin, ensure your spore syringe is properly prepared and free from contaminants. Hold the syringe vertically, with the needle pointing upward, to allow any air bubbles to rise to the top. Gently tap the syringe to consolidate the spore solution at the bottom, minimizing the risk of injecting air into your agar. This simple action can significantly reduce the chances of introducing impurities, as air bubbles can disrupt the sterile environment and affect the growth of your mycelium.
In the extraction process, the goal is to transfer a controlled amount of spore solution onto the agar surface. A common technique is to use a 10–20 ml syringe, from which you’ll typically extract 0.1–0.5 ml of solution per inoculation site. To achieve this, slowly depress the plunger while monitoring the flow. Stop immediately once the desired volume is dispensed, as over-extraction can lead to spillage or contamination. For beginners, practicing this motion with sterile water beforehand can help refine your technique and build confidence.
Comparing methods, some cultivators prefer using a sterile needle to create a small well in the agar before depositing the spore solution. This approach ensures the solution remains localized, reducing the risk of surface runoff. However, this method requires additional precision and may not be suitable for all agar types. Alternatively, a direct surface inoculation technique involves gently touching the needle to the agar and releasing the solution in a controlled droplet. Both methods have their merits, but the key lies in maintaining sterility throughout the process.
A critical caution is to avoid touching the needle to the inside of the syringe cap or any non-sterile surface. Even the slightest contact can introduce impurities, rendering your spore solution unusable. Always handle the syringe with gloved hands and work within a sterile environment, such as a still-air box or laminar flow hood. Additionally, ensure the agar has cooled sufficiently (around 45–50°C) before inoculation, as excessive heat can damage the spores or cause the agar to melt, leading to uneven distribution.
In conclusion, extracting spore solution carefully from the syringe is a delicate balance of precision and control. By mastering this step, you lay the foundation for a successful inoculation, ensuring the purity and viability of your culture. Whether you’re a novice or an experienced cultivator, attention to detail and adherence to sterile practices will yield the best results. Remember, the goal is not just to transfer spores but to do so in a way that preserves their integrity and maximizes their potential for growth.
Mastering Rogue Tactics: A Comprehensive Guide to Dominating Spore's Universe
You may want to see also

Inject spores into agar using proper technique to ensure even distribution
Inoculating agar with a spore syringe requires precision to achieve uniform spore distribution, a critical factor for successful mycelial growth. The technique hinges on delivering a consistent volume of spore solution—typically 1-2 cc—into the agar while minimizing contamination. Begin by sterilizing the injection site with a flame or alcohol swab to create a barrier against external microbes. Insert the syringe needle at a 45-degree angle, no more than 0.5 inches deep, to avoid piercing through the agar. Slowly depress the plunger, allowing the spores to disperse evenly within the gel-like medium. This method ensures that spores are not concentrated in one area, promoting balanced colonization.
The choice of injection depth and angle is not arbitrary; it directly influences spore dispersion. Too shallow, and the spores may pool on the surface; too deep, and they risk clustering at the needle’s entry point. A 45-degree angle strikes a balance, facilitating lateral spread within the agar’s matrix. Additionally, warming the agar plate to room temperature before inoculation reduces its viscosity, aiding in spore mobility. This simple step, often overlooked, can significantly enhance distribution uniformity, especially when working with thicker agar formulations.
Contamination remains the primary adversary in this process, demanding meticulous attention to sterile technique. After withdrawing the needle, immediately seal the injection site with a sterile cotton swab or alcohol-soaked applicator. Some cultivators prefer using a self-healing injection port, such as a silicone stopper, to minimize exposure. Regardless of the method, maintain a clean workspace and use a laminar flow hood if available. Even a single stray microbe can outcompete the spores, rendering the agar unusable.
Mastering spore injection is as much about patience as it is about technique. After inoculation, resist the urge to disturb the agar plate. Vibrations or movement can cause spores to settle unevenly, defeating the purpose of careful injection. Incubate the plate in a stable, dark environment at 70-75°F (21-24°C), allowing 7-14 days for colonization. Regularly inspect for signs of contamination or uneven growth, adjusting your technique accordingly in future attempts. With practice, this method becomes second nature, yielding consistently robust mycelial networks.
Ionized Air Fans: Effective at Capturing and Eliminating Spores?
You may want to see also

Seal and incubate plates in optimal conditions for spore germination and growth
Once the agar plates are inoculated with spores, sealing and incubating them under optimal conditions is critical to ensure successful germination and growth. Proper sealing prevents contamination and retains moisture, while precise incubation conditions mimic the spores' natural environment, fostering development. Use parafilm or microwave-safe plastic wrap to seal plates tightly, ensuring no gaps allow airborne contaminants or moisture loss. Alternatively, some cultivators prefer sealing plates with their lids and securing them with tape for added protection.
Incubation conditions vary by species, but most spores thrive in temperatures between 75°F and 85°F (24°C–29°C) with 60–70% humidity. Place sealed plates in a dark, undisturbed area, such as a still air box or incubator, to maintain consistency. Avoid direct sunlight or temperature fluctuations, which can stress the spores and inhibit growth. For species like *Psilocybe cubensis*, a 12–24 hour incubation period often shows initial signs of germination, with full colonization taking 7–14 days.
Analyzing the incubation process reveals that temperature is the most influential factor. Even a 2°F deviation can delay germination or promote mold growth. Humidity, while secondary, ensures the agar remains hydrated, preventing desiccation of the spores. For example, if the incubation area is naturally dry, placing a tray of water nearby can help maintain optimal moisture levels. Monitoring these conditions with a thermometer and hygrometer is essential for consistent results.
A persuasive argument for investing in a dedicated incubator is its ability to automate temperature and humidity control, reducing human error. While DIY setups work, they require vigilant monitoring and adjustments. For hobbyists or small-scale cultivators, a simple still air box with a heating pad and hygrometer offers a cost-effective solution. However, for long-term or large-scale projects, an incubator ensures reliability and scalability.
In conclusion, sealing plates with parafilm or plastic wrap and incubating them in a dark, temperature-controlled environment is non-negotiable for spore germination. Tailor conditions to the species, monitor closely, and consider investing in tools that maintain consistency. By optimizing these steps, cultivators can maximize success rates and set the stage for healthy mycelial growth.
Milky Spore for Mole Control: Effective Solution or Myth?
You may want to see also
Frequently asked questions
Inoculating agar with a spore syringe introduces fungal spores into a sterile agar medium, allowing them to germinate and grow into mycelium, which can then be used for further cultivation or study.
Clean your workspace with a 70% isopropyl alcohol solution or another disinfectant. Use a laminar flow hood or still air box if available, and ensure all tools (e.g., scalpel, syringe) are sterilized with a flame or alcohol before use.
Flame-sterilize the syringe needle, then insert it through the injection port of the agar container. Dispense a small amount of spore solution (0.5–1 mL) into the agar, being careful not to contaminate the surface. Flame the needle again after use.
Growth time varies by species, but typically, visible mycelium appears within 7–14 days under optimal conditions (e.g., 22–28°C or 72–82°F). Ensure the agar is stored in a dark, sterile environment during incubation.







